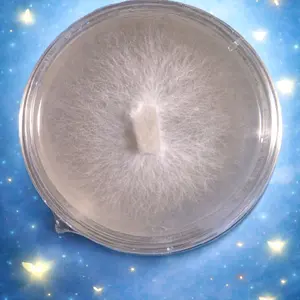
Lions Mane Culture Plate

Results for "galvanized plate"
A galvanized plate is a steel plate that has been coated with a layer of zinc to prevent rust and corrosion. This makes it a durable option for various applications, including motorcycle accessories.

$35.00


5.0
151 sold
-10%$89.46$99.41


Related Searches
Related Categories
Introduction
When it comes to motorcycle accessories, durability is key, and that's where galvanized plates shine. A galvanized plate is a steel plate coated with zinc, providing excellent protection against rust and corrosion. This makes it an ideal choice for various motorcycle accessories, ensuring they can withstand the elements and maintain their integrity over time.
Using galvanized plates in motorcycle accessories not only enhances their longevity but also adds to their strength. Whether you're looking for mounting brackets, footpegs, or other components, opting for galvanized materials means you're investing in quality that is trusted by thousands of riders.
Here are some benefits of using galvanized plates in motorcycle accessories:
When selecting motorcycle accessories, consider those made with galvanized plates for proven quality and performance. Regularly updating your motorcycle gear with durable materials ensures you're always ready for the road ahead.
Using galvanized plates in motorcycle accessories not only enhances their longevity but also adds to their strength. Whether you're looking for mounting brackets, footpegs, or other components, opting for galvanized materials means you're investing in quality that is trusted by thousands of riders.
Here are some benefits of using galvanized plates in motorcycle accessories:
- Corrosion Resistance: The zinc coating protects the steel from moisture and environmental factors.
- Durability: Galvanized plates are built to last, making them a reliable choice for heavy-duty applications.
- Cost-Effective: They offer a long lifespan, reducing the need for frequent replacements.
- Versatility: Suitable for a variety of motorcycle accessories, enhancing their functionality.
When selecting motorcycle accessories, consider those made with galvanized plates for proven quality and performance. Regularly updating your motorcycle gear with durable materials ensures you're always ready for the road ahead.


































